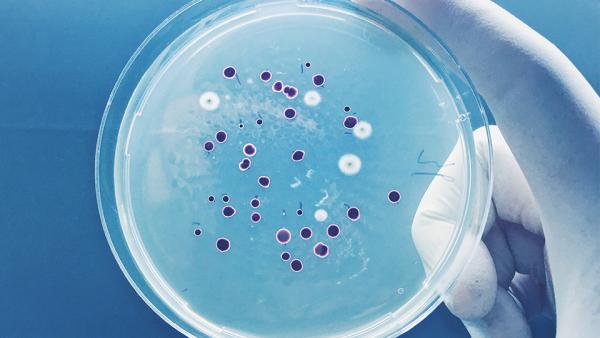

Guide de survie face au patient immunodéprimé en réanimation
Formation en ligne
Journée de formation en distanciel
organisée par le Comité de Coordination et d’Organisation des Formations de la SRLF
Venez tester vos connaissances sur la gestion du patient immunodéprimé en réanimation !
Un programme en e-learning et des quizz suivis d’un live autour de cas cliniques interactifs.
Vous trouverez, sur la page Formations et Séminaires :
- Accueil des personnes en situation de handicap
- Conditions d'accès sanitaire aux formations
- Conditions Générales de Vente
- Règlement intérieur des Formations
Pour tout renseignement complémentaires ou pour un besoin spécifique, n'hésitez pas à nous contacter via la rubrique contact.

Objectifs pédagogiques
- Savoir évaluer le risque infectieux en fonction du type d’immunosuppression.
- Savoir gérer les immunosuppresseurs chez le patient greffé admis en réanimation.
- Connaître la démarche diagnostique de l’insuffisance respiratoire aiguë du patient immunodéprimé.
- Connaître les complications de l’immunothérapie pouvant conduire en réanimation.
Modalités pédagogiques
- Vidéos et quizz
- Étude de cas cliniques interactifs
- Exposé participatif
Modalités d’évaluation
- Quizz avant / après
Population concernée
- Internes, médecins, paramédicaux exerçant en réanimation
Prérequis :
Soignants souhaitant approfondir leurs connaissances du patient immunodéprimé en soins critiques et développer leurs compétences pour la prise en charge de ces patients.
Tarifs
| Membres de la SRLF* Membres Jeunes de la SRLF* Membres Paramédicaux de la SRLF* Médecins non Membre de la SRLF Institutions**** |
75,00 €** 50,00 €** 25,00 €** 200,00 €** 200,00 €**** |
* La cotisation 2022 doit être à jour pour bénéficier du tarif "Membre".
** Les frais de participation sont à régler en ligne, par carte bancaire, au moment de l'inscription.
Ces prix s’entendent toutes taxes comprises.
*** Un justificatif étudiant devra être transmis pour valider l'inscription
****Pour les services de formation, une convention sera établie au nom de l’agent et la facturation se fera post formation.
Programme e-learning
4 vidéos à visionner avant le live + quizz
- Quel risque infectieux selon le type d’immunodépression ? I Emmanuel Canet (Nantes)
- Gestion des immunosuppresseurs chez le patient greffé d’organe admis en réanimation I Lara Zafrani (Paris)
- Diagnostic des complications pulmonaires chez le patient immunodéprimé I Naïke Bigé (Villejuif)
- Complications de l’immunothérapie à connaître en réanimation I Olivier Lambotte (Bicêtre)
Programme live - le 15 novembre (14h00 > 17h00)
14h00 > 14h05 Accueil des participants
14h05 > 14h35 Orientation diagnostique et scanner thoracique de l’immunodéprimé - Cendrine Godet (Paris)
14h35 > 15h05 Cas clinique autour d’un patient d’hématologie – Frédéric Pène (Paris)
15h05 > 15h35 Cas clinique autour d’un patient porteur d’une tumeur solide – Clara Vigneron (Paris)
15h35 > 16h05 Cas clinique autour d’un patient greffé – Lara Zafrani (Paris)
16h05 > 16h35 Cas clinique autour d’un patient sous immunothérapie - Olivier Lambotte (Bicêtre)
16h35 > 17h00 Conclusion et fin de formation